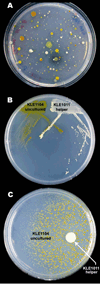

Siderophores from neighboring organisms promote the growth of uncultured bacteria
- PMID: 20338517
- PMCID: PMC2895992
- DOI: 10.1016/j.chembiol.2010.02.010
Siderophores from neighboring organisms promote the growth of uncultured bacteria
Abstract
The majority of bacterial species do not grow on synthetic media. Many non-growers require growth factors from other bacteria, but the nature of these compounds is largely unknown. We show here that previously uncultured isolates from marine sediment biofilm grow on a Petri dish in the presence of cultured organisms from the same environment. The growth factors produced by one cultured helper strain were identified as new acyl-desferrioxamine siderophores. A panel of previously uncultured isolates exhibited a range of siderophore promiscuity for growth promotion. This siderophore-based approach has enabled the culturing of organisms only distantly related to previously cultured microbes. The lack of growth in the laboratory for many strains from this habitat stems from an inability to autonomously produce siderophores, and the resulting chemical dependence on other microorganisms regulates community establishment in the environment.
Copyright 2010 Elsevier Ltd. All rights reserved.
Figures

References
Publication types
MeSH terms
Substances
Associated data
- Actions
- Actions
- Actions
- Actions
- Actions
- Actions
- Actions
- Actions
- Actions
- Actions
- Actions
- Actions
- Actions
- Actions
- Actions
- Actions
- Actions
- Actions
- Actions
- Actions
- Actions
- Actions
- Actions
- Actions
- Actions
- Actions
Grants and funding
LinkOut - more resources
Full Text Sources
Other Literature Sources
Molecular Biology Databases

